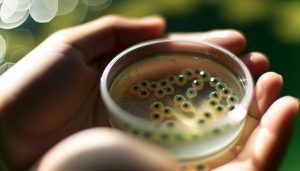

Entdecke die Welt des Angelns
Willkommen auf unserer Plattform für Angler und Naturfreunde. Hier findest du wertvolle Insights und Tipps für dein nächstes Abenteuer.
Über uns

Mission und Werte
Unsere Mission ist es, eine informative Plattform für Fans des Angelns und aquatischer Lebensformen zu sein. Wir setzen uns dafür ein, Wissen zu teilen und nachhaltige Praktiken zu fördern, um die Freizeitgestaltung in der Natur zu verbessern.
Engagement für die Community
Wir glauben an die Stärke der Gemeinschaft. Gaisbock schafft einen Raum, in dem sich Angler und Liebhaber des aquatischen Lebens austauschen und voneinander lernen können, um ihr Wissen zu erweitern.
Nachhaltigkeit im Fokus
Nachhaltigkeit ist uns wichtig. Wir fördern verantwortungsbewusste Praktiken, um die Gewässer und Ökosysteme zu schützen, die uns am Herzen liegen. Gemeinsam können wir einen positiven Einfluss auf unsere Umwelt ausüben.
Artikelveröffentlichungen
Entdecken Sie fundierte Artikel zu verschiedenen Angeltechniken und Aquarienpflege. Unser Ziel ist, Sie mit wertvollen Informationen zu unterstützen.
Experteninterviews
Lernen Sie von den Besten in der Branche. Unsere Interviews geben Ihnen Einblicke in die Erfahrungen erfahrener Angler und Aquarianer.
Tipps & Tricks
Nutzen Sie unsere praktischen Tipps, um Ihre Angeltechniken zu verbessern und Ihre Aquarien optimal zu betreuen.
Community-Events
Nehmen Sie an unseren Veranstaltungen teil, um Gleichgesinnte zu treffen und Ihr Wissen zu erweitern. Gemeinsam macht das Angeln mehr Spaß.
Ratgeber & Ressourcen
Greifen Sie auf nützliche Ratgeber zu, die Ihnen helfen, Ihr Wissen über verschiedene Fischarten und Aquarientechniken zu vertiefen.
Fragen & Antworten
Haben Sie Fragen? Unsere FAQ bietet Antworten auf häufig gestellte Fragen zu Angeln und Aquaristik.
Aktuelle Artikel aus unserem Magazin

Am Lech fischen und campen: Abenteuer in der Natur erleben
Entdecke das Abenteuer “Am Lech fischen und campen”: Erlebe unvergessliche Naturmomente! Hol dir Expertentipps für ein unvergessliches Erlebnis. Jetzt informieren!
Was Ist Ein Dottersack Bei Fischen: Frühentwicklung Entdecken
Entdecke, was ein Dottersack bei Fischen ist! Lerne die faszinierende Frühentwicklung und ihre Bedeutung für die Aquakultur kennen. Verpasse nicht diese Einblicke!

Was bedeuten schnelle Bewegungen bei Fischen? Körpersprache entschlüsseln
Entschlüsseln Sie die Körpersprache von Fischen: Was bedeuten schnelle Bewegungen? Entdecken Sie faszinierende Verhaltensweisen und Tipps für Ihr Angel-Erlebnis!

Wann kommt Fremd Fischen 2: Release-Termin & Trailer 2025
Entdecke alles über “Wann kommt Fremd Fischen 2: Release-Termin & Trailer 2025”! Finde jetzt heraus, wann das Warten ein Ende hat und sichere dir exklusive Einblicke!

Warum sitzen die Kiemen bei Fischen dicht beieinander? Funktion erklärt
Entdecken Sie die faszinierende Funktion der dicht beieinander sitzenden Kiemen bei Fischen! Erfahren Sie, wie sie das Überleben im Wasser sichern. Jetzt lesen!

Wo darf man in Bremen Angeln? Infos zu Gewässern und Regeln
Entdecken Sie die besten Angelplätze in Bremen! Holen Sie sich alle Infos zu Gewässern, Regeln und Tipps für Angler – direkt hier!

Welche Fische kann man im Februar angeln: Winterangeln richtig machen
Entdecken Sie, welche Fische man im Februar angeln kann! Lernen Sie die besten Winterangeltechniken und maximieren Sie Ihren Fang. Jetzt informieren und erfolgreich angeln!
Wie viele Angeln gleichzeitig sind erlaubt? Klare Antworten
Finde heraus, wie viele Angeln gleichzeitig erlaubt sind! Entdecke die wichtigsten Regeln, die dir helfen, legal und erfolgreich zu angeln. Jetzt informieren!

Warum ist Dynamitfischen verboten? Regeln und Gefahren
Entdecke, warum Dynamitfischen verboten ist! Lerne die gefährlichen Auswirkungen und die Regeln, die unsere Gewässer schützen. Klicke jetzt für mehr Infos!

Welche Fische im Winter angeln: Arten ohne Schonzeit
Entdecke, welche Fische im Winter angeln: Arten ohne Schonzeit! Lerne die besten Techniken und falle auf in deinen Angler-Momenten. Jetzt informieren und fangen!

Was Darf Ich An Fischen Fangen Am Todnitzsee Bestensee: Regeln & Tipps
Entdecke die besten Tipps und Regeln für das Angeln am Todnitzsee in Bestensee! Finde heraus, was du fangen darfst und starte dein unvergessliches Angelerlebnis!

Was ist Finesse Angeln: Sanfte Techniken für zielsicheren Erfolg
Entdecken Sie Finesse Angeln: Sanfte Techniken für zielsicheren Erfolg! Lernen Sie, wie Sie mit cleveren Methoden große Fische fangen können. Ihr Angelerlebnis wartet!

Wo kann man in Österreich ohne Angelschein angeln: Infos
Entdecke die besten Spots in Österreich, wo du ohne Angelschein angeln kannst! Lerne alles über kostenlose Angelmöglichkeiten und finde deinen perfekten Platz!

Wann kann man Heringe angeln – Heringssaison nicht verpassen
Entdecke, wann man Heringe angeln kann! Verpasse nicht die beste Zeit der Heringssaison. Finde heraus, welche Hotspots und Techniken dich zum Erfolg führen!

Wo kann man angeln in der Nähe: Lokale Hotspots finden
Entdecken Sie, wo man angeln in der Nähe die besten Hotspots findet! Lernen Sie die besten Tipps und Techniken, um unvergessliche Angelausflüge zu erleben!

Warum fressen Fische die Augen anderer? Erstaunliche Gründe
Warum fressen Fische die Augen anderer? Entdecken Sie die erstaunlichen Gründe hinter diesem faszinierenden Verhalten. Lassen Sie sich überraschen!

Wie ist das Wetter in Fischen: Angelwetter-Prognose optimiert
Entdecke in unserer optimierten Angelwetter-Prognose, wie das Wetter in Fischen ideale Bedingungen für dein nächstes Angelabenteuer schafft! Erlebe den Unterschied!

Wo kann man Störe angeln: Drill-Erlebnis XXL wartet
Entdecken Sie die besten Orte, wo man Störe angeln kann! Erleben Sie ein unvergessliches Drill-Erlebnis XXL – holen Sie sich Ihren Traumfisch!

Wann darf man Hecht angeln – Schonzeit in allen Bundesländern
Erfahre, wann du Hecht angeln darfst! Jetzt die Schonzeiten in allen Bundesländern entdecken und ideal vorbereiten. Lass dir diese top Tipps nicht entgehen!

Mit der Exakta Varex unter Fischen und Fallschirmspringern
Entdecken Sie, wie Sie mit der Exakta Varex atemberaubende Unterwasser- und Fallschirmsprung-Fotografien realisieren! Lernen Sie Techniken, die Ihre Aufnahmen revolutionieren.

Mit welchen Fischen kann man Purpurprachtbarsche zusammen setzen: Sozialverträgliche Tipps
Entdecken Sie, mit welchen Fischen Sie Purpurprachtbarsche artgerecht zusammen setzen können! Holen Sie sich sozialverträgliche Tipps für ein harmonisches Aquarium.
Abonniere unseren Newsletter!
Bleibe informiert über die neuesten Tipps und Trends rund ums Angeln und aquatisches Leben. Erhalte regelmäßig spannende Inhalte direkt in deinem Postfach!
Häufige Fragen
Hier finden Sie Antworten auf häufige Fragen rund ums Angeln und aquatisches Leben.

Der beste Angelplatz hängt von mehreren Faktoren ab, einschließlich der Jahreszeit, des Wetters und der Fischarten, die Sie fangen möchten. Recherchieren Sie lokale Gewässer, sprechen Sie mit anderen Anglern und nutzen Sie Online-Ressourcen, um die besten Spots zu finden.
Die besten Zeiten zum Angeln variieren je nach Fischart. Allgemein gilt, dass frühe Morgenstunden oder der späte Abend ideale Zeiten sind, wenn die Fische aktiver sind und sich an der Oberfläche bewegen.
Die Grundausstattung beinhaltet eine Angelrute, eine Rolle, Angelschnur, Köder und eine Tasche. Je nach Zielfisch kann spezielle Ausrüstung nötig sein, etwa Fliegenfischen oder Hochseeangeln.
Gute Angeltechniken lernen Sie durch Erfahrung und Beobachtung. Suchen Sie nach Ressourcen wie Online-Tutorials oder Kursen und erfahren Sie von anderen Anglern vor Ort. Übung ist der Schlüssel zur Verbesserung.
Um die Gewässer zu schützen, sollten Sie Ihren Müll ordnungsgemäß entsorgen, keine invasiven Arten einbringen und lokale Vorschriften beachten. So tragen Sie zu einem gesunden Ökosystem bei.